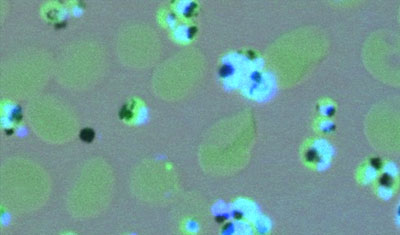

Ngày 10/4/2015. Malaria News - Có thể có một xét nghiệm dành cho bệnh sốt rét dễ dàng như một xét nghiệm hơi thở? (Could a test for malaria be as easy as a breathalyzer?). Một nhóm các nhà khoa học ở Missouri đang nghiên cứu một phương pháp mang tính đột phá để xét nghiệm căn bệnh đó và nếu thành công, có thể tiết kiệm thời gian, tiền bạc và quan trọng nhất là mạng sống.Nó là gì? Một xét nghiệm hơi thở kiểu bệnh sốt rét.
Hơn nửa triệu người chết vì sốt rét mỗi năm, hầu hết là trẻ em dưới 5 tuổi ở châu Phi và trong những nơi mà bệnh sốt rét lưu hành nhiều nhất thì xét nghiệm sốt rét vẫn còn tương đối đắt tiền để chẩn đoán. Tuy nhiên, một nhóm các nhà khoa học ở Missouri đang nghiên cứu một phương pháp mang tính đột phá để xét nghiệm căn bệnh đó và nếu thành công, có thể tiết kiệm thời gian, tiền bạc và quan trọng nhất là mạng sống. "Nếu bạn có thể chẩn đoán [trẻ em bị sốt rét] sớm hơn và làm cho chúng được điều trị sớm hơn vì các nghiên cứu cho biết khá rõ ràng là điều trị sớm sẽ làm giảm tỷ lệ tử vong đáng kể", Audrey Odom, Phó giáo sư nhi khoa và vi sinh học phân tử tại Đại học Washington ở St. Louis cho biết. Hiện vẫn còn nhiều việc cần phải làm nhưng kết quả mà Odom và nhóm của bà tại Đại học Washington thực hiện cho đến nay là đầy hứa hẹn. Nghiên cứu của họ, gần đây đã được công bố trên tạp chí mBio cho thấy ký sinh trùng sốt rét tạo ra một lớp các hợp chất mà có thể thu hút muỗi có nghĩa là nếu muỗi có thể ngửi thấy mùi của các hợp chất được sinh ra khi bị sốt rét và sau đó họ cũng sẽ có thể phát hiện qua xét nghiệm không xâm lấn tương tự như mùi của một hơi thở mà không cần một mẫu soi kính hiển vi hoặc mẫu máu.
 |
| Con người thu hút muỗi bởi các yếu tố khác nhau, bao gồm carbon dioxide, nhiệt và mùi |
"Các hợp chất mà chúng tôi tìm thấy đã được mô tả trong các tài liệu như chất hấp dẫn muỗi ở nồng độ thấp", bà giải thích: "Ở nồng độ cao, chúng là những chất xua muỗi vì vậy chúng tôi nghĩ rằng có rất nhiều loại như nước hoa dùng cho con người,đôi khi một chút mùi thơm và có rất nhiều thuốc xua côn trùng". Một phần của những gì mà nghiên cứu được nhắc nhở là nghiên cứu trước đây chỉ ra rằng muỗi có nhiều khả năng đốt những người đã bị bệnh sốt rét,điều này sẽ có lợi cho ký sinh trùng vì nó không thể di chuyển từ người sang người bởi chính nó. Thay vào đó, bệnh sốt rét lây lan khi một con muỗi đốt một ai đó đã có ký sinh trùng bị nhiễm bệnh, sau đó đốt người khác.
|
| Các tế bào hồng cầu người nhiễm sốt rét |
"Có những nghiên cứu ở trẻ em, ở chuột và cũng ở chim cho thấy rằng muỗi sẽ chọn để đốt một ngườibị nhiễm sốt rét chứ không phải ở một người khôngbị nhiễm và thực sự vì thế mà cho rằng có điều gì đó khi sốt rét gây nhiễm cho con người mà có thể thoát ra khỏi cơ thể", Odom nói: "Vì vậy, chúng tôi đã đi tìm kiếm để xem liệu chúng tôi có thể tìm thấy chúng". Những gì họ tìm thấy là ký sinh trùng có chứa các bào quan giống như hình lục lạp mà không đáp ứng với ánh sángnhưng sản xuất ra một lớphợp chất gọi là tecpen. Hai ví dụ về tecpen là pinen, đó là những gì mà cây thông cho mùi hương đặc biệt và limonene, chịu trách nhiệm về các mùi đặc trưng của chanh. Trong khi số lượng các hợp chất mà các nhà nghiên cứu tìm thấy là không đủ đáng kể cho con người ngửi thấy nhưng chúng có thể được phát hiện bởi muỗi. Những con côn trùng ghét cay ghét đắng khi bị thu hút tới mục tiêu của chúng bằng một loạt các yếu tố, bao gồm carbon dioxide, cơ thể ấm áp, và mùi hôi. Muỗi sẽ được thu hút bởi đôi chân có mùi hôi và thậm chí cả pho mát Limburger, Odom cho biết.
Việc phát hiện ra loại sốt rét này tạo ra "nước hoa chống muỗi" (mosquito perfume) hiện nay trên cơ sở phòng thí nghiệm, những kết quả này cần được nhân đôi trong thực tế để được công nhận vì vậy Odom và nhóm của bà đang có các kế hoạch thử nghiệm thực địa tại Malawi để thu lấy hơi thở và mồ hôi ở những trẻ em có và không có bệnh sốt rét để tìm kiếm liệu các hợp chất có thể được phát hiện ở người bị nhiễm sốt rét hay không. Tại thời điểm này, các bác sĩ có thể xét nghiệm bệnh sốt rét bằng một xét nghiệm máu hoặc sử dụng test chẩn đoán nhanh. Xét nghiệm máu đòi hỏi một mẫu máu, một kính hiển vi, và một người được đào tạo để chuẩn bị và đọc các mẫu bệnh phẩm. Test chẩn đoán nhanh có giá rẻ theo tiêu chuẩn Mỹ (khoảng một đô la), nhưng có thể tốn kém khi sử dụng ở quy mô lớn tại các nước trong tiểu vùng Saharan châu Phi, nơi mà bệnh sốt rét là phổ biến nhất. Nơi mà bệnh là phổ biến nhất thì các bác sĩ sẽ điều trị sốt rét cho bất kỳ đứa trẻ bị sốt thay vì cố gắng xét nghiệm bệnh, cách tiếp cận này có xu hướng trở nên có hiệu quả hơn khi có rất nhiều trẻ em mắc căn bệnh này nhưng khi tỷ lệ nhiễm giảm xuống thì nó trở nên khó giải quyết hơn. Sử dụng quá nhiều thuốc chống sốt rét đang giúp đỡ sản xuất ra các phiên bản của bệnh mà chúng có khả năng kháng với các loại thuốc phổ biến hơn và ít đắt tiền.
 |
| Phụ nữ chăm sóc các đứa con bị bệnh trong khi chúng được chữa trị bệnh sốt rét ở bệnh viện thành phố của M'banza-Kongo, thủ phủ của tỉnh Zaire nằm ở phía Tây Bắc Angola, vào năm 2006. Ảnh: Alison Bird/USAID |
"Chúng tôi đang thực hiện và bỏ đi rất nhiều thuốc chống sốt rét cho trẻ em không cần thuốcvà điều đó là không tốt cho sự đề kháng và cũng là thực sự tốn kém", Odom nói: "Vì vậy, để tiết kiệm đô la cho trẻ em thực sự bị bệnh, một phương pháp xét nghiệm rất rẻ dễ dàng có thể là rất quan trọng, đặc biệt là ở những nơi có ít bệnh sốt rét,bạn thực sự có thể có thể đi đến một tình huống loại trừ bệnh sốt rét". Ý tưởng sử dụng hơi thở hoặc ngửi để xét nghiệm đối với các căn bệnh có ảnh hưởng rộng, Odom cho rằng nghiên cứu khác đã chỉ ra một hợp chất trong hơi thở của những người bị viêm phổi do nấm mà các bác sĩ cũng có thể có thể phát hiện bằng xét nghiệm giống như hơi thở. Cuối cùng, Odom đã trích dẫn một lý do tại sao xét nghiệm như vậy có thể được ưa thích bởi cả trẻ em và người lớn vì chúng không liên quan đến bất kỳ việc sử dụng bằng kim chích